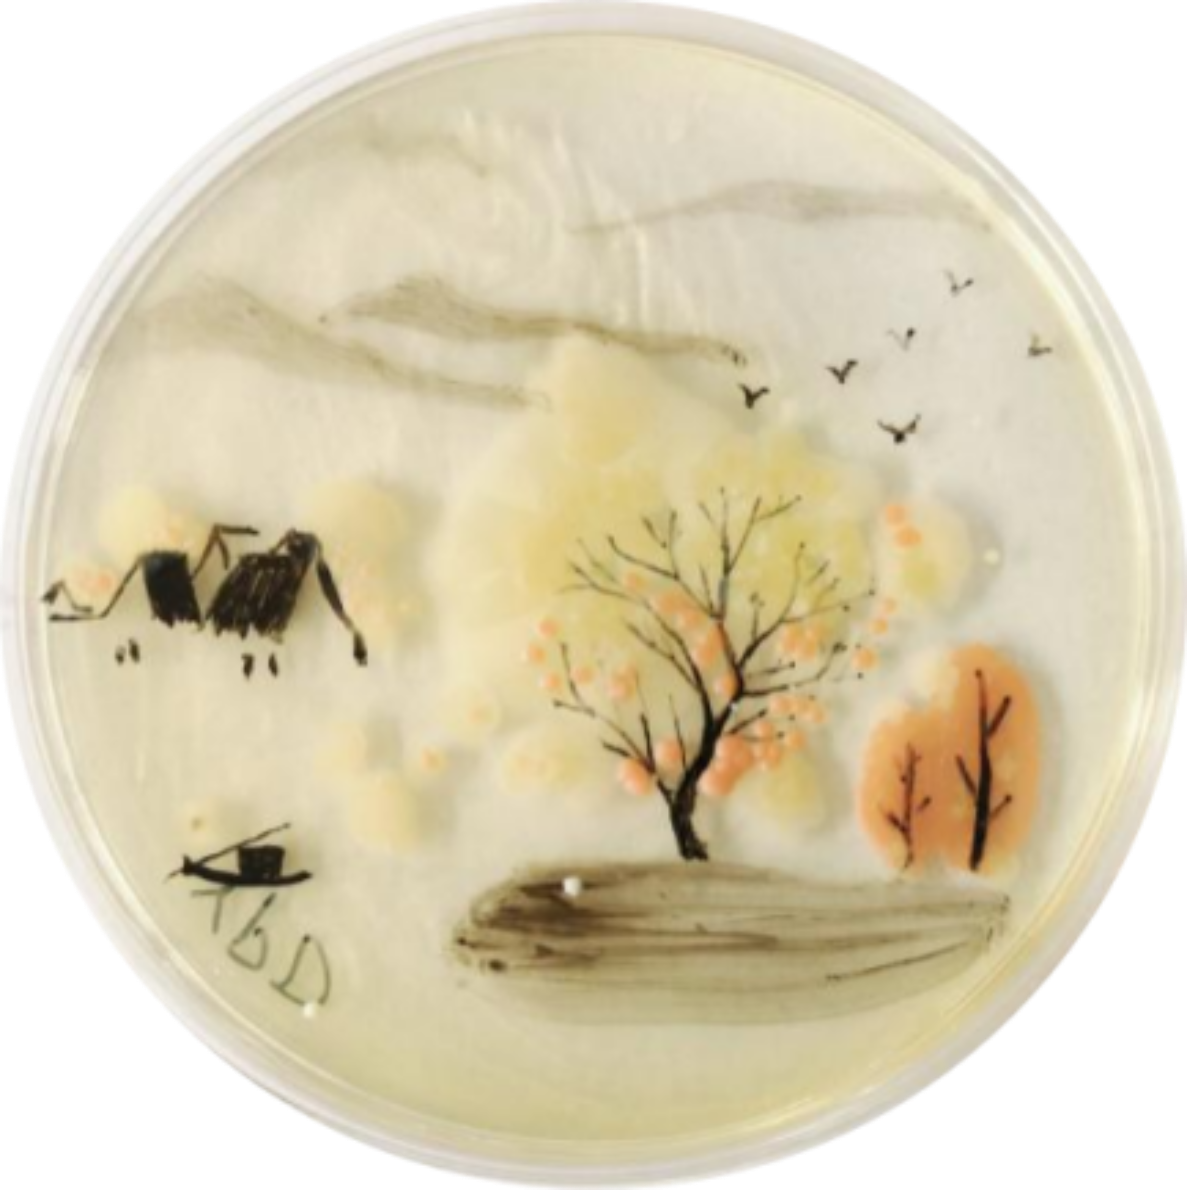

发布时间:2021-06-20 浏览量: 作者:羊沛 申莉 来源: 生物学院
为迎接建党100周年、赓续红色革命精神,进一步浓厚学校创新创业氛围,推动微生物科学知识普及,生物工程学院、生物工程国家级实验教学示范中心联合校团委以庆祝建党100周年为契机,深入挖掘专业课程思政元素,充分发挥我校微生物领域优势特色,依托发酵工程国家重点学科、“生物工程”和“制药工程”两个国家级一流专业建设点、以及“微生物学”国家级一流课程,于4月至6月开展“喜迎建党100周年系列活动之第六届天津科技大学微世界艺术大赛”。
6月11日,“第六届微世界艺术大赛决赛暨颁奖典礼”在滨海中校区9号楼举行。学校组织部、校团委、教务处、研究生院、艺术学院、马克思主义学院、生物工程学院负责同志,微生物学专业课教师代表,以及往届全国竞赛金奖获奖代表出席比赛并担任评委。
第六届天津科技大学微世界艺术大赛经组委会宣讲、往届优秀选手分享经验、创作技能和经验指导、学生积极报名,共有126组同学参赛,来自各个学院的本科生和研究生参加学生数近400人,初赛提交作品260幅。参赛选手用微生物在培养皿上作画,用“微世界”表达“大艺术”,形成了专业知识和艺术魅力的完美融合,实现了理论知识与实践能力的有机统一。
作者:朱韶英,赵嘉琪,马艺宁
远山朦胧雁飞去,近水淙淙扁舟行。

作者:赵楠,周隽涵,于敏
中国持续发展,勇攀科技高峰,正在一步一个脚印开启星际探测新征程。中国人民航空事业百折不挠的精神,终会开拓到宇宙的每一个未知角落。

作者:史京辉,王宇,梁景涵
百年风雨红船渡,峥嵘岁月浅笑谈。今朝承荫前人甘,明朝再起腾龙时。

作者:朱韶英,马艺宁,赵嘉琪
兽面衔环

作者:张艺琳,孟燕,修鹤洋
展望激情冬奥会,我们用一颗颗炽热的心融化坚实的冰,让这个冬天不再寒冷。

作者:李梦涵,韩蓓
听党话,跟党走,一颗红心永向党!

作者:张雯,叶春婷
《1921》——党旗前的共产党人举起右臂,庄严宣誓,他坚定的眼神中透露着共产党人的初心,握紧的右拳彰显责任与担当,笔直的身躯展示青春与活力,坚实的臂膀背负着中华民族伟大复兴的历史使命!

作者:张淑慧,吴程远,杜路畅
国宝怀抱地球,中国胸怀生态。心系人类命运,营造生命绿洲。
华夏儿女在行动!

作者:赵一龙,陈林,杨凤军
新疆采棉花姑娘:银光点染兆年丰,万顷星摇似雪融。人间盛世乐祥和,赤县同吟感谢歌。

作者:童婧,许凌欣,吴亮楷
红船辟浪渡关山,万里长风从未还。
初赛作品经天津农学院、齐鲁工业大学、北京协和医院、天津市肿瘤医院、安琪酵母股份有限公司、丹娜生物科技股份有限公司、天津海关动植物与食品检测中心等单位的专家,以及学校团委、教务处、食品学院、马克思主义学院、艺术设计学院相关教师的专业评审,共有23组作品脱颖而出进入决赛。
23组同学从作品名称、创作理念、实验过程记录及心得体会等方面分享参赛的所感所获。紧扣“喜迎建党100周年”主题,同学们结合时政,作品中有建党百年、有红船精神、有抗疫英雄、有边防战士、有冬季奥运,有一带一路、有生态保护、有大国航天梦、也有恬静山水图......每一幅细致精彩的作品都获得台下评委热烈的掌声。
会上,生物工程学院党委副书记、院长罗学刚对大赛作品进行点评,对大学生们充分发挥专业所长,奇思妙想的精致微生物画作表示高度赞赏,认为作品充分体现了大家对专业的理解和热爱。微世界艺术大赛是艺术和美的融合,是专业素养的展示、是德智体美劳五育并行的体现,是课程思政实践育人落地的声音。罗学刚寄语大家认真学习知识,提高实践能力,提升综合素质,勤学善思,不断构建专业自信,取得更大的成绩。
微世界,大艺术。当微小生物遇上家国情怀,微生物的细微之美与家国的宏伟之美迸发出了独特的魅力!同学们以微生物为原料,以移液器为画笔,以培养皿为画卷,奇思妙想勾勒出一幅幅艺术作品,用实际行动践行着“尚德尚学尚行、爱国爱校爱人”的校训精神,以“知行合一、至善求是”的生物精神献礼建党一百周年。